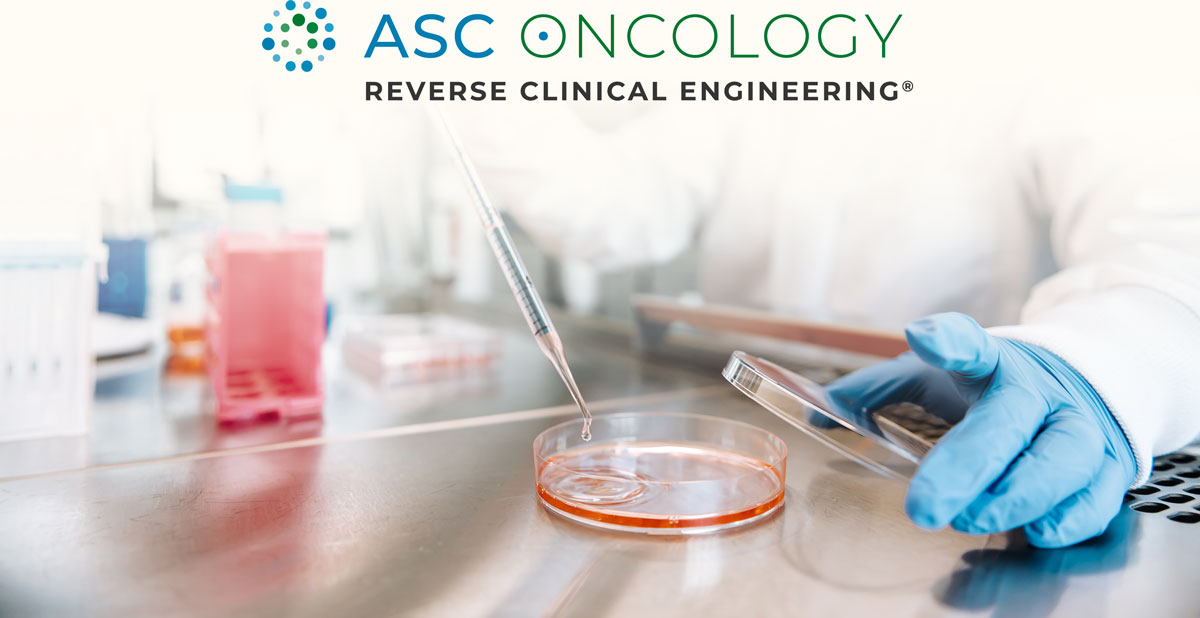

Reverse Clinical Engineering
Mit In-vitro-Diagnostik an Patienten-abgeleiteten 3D-Tumormodellen zur modernen Präzisionsonkologie
Mit dem Reverse Clinical Engineering® (RCE) hat ASC Oncology ein ergänzendes Testverfahren entwickelt, mit dem überprüft werden kann, welche medikamentösen Krebstherapien beim individuellen Patienten mit malignem soliden Tumor mit hoher Wahrscheinlichkeit wirken und welche nicht. Die Methode zählt zu den In-vitro-Diagnostika und basiert auf Patienten-abgeleiteten 3D (PD3D®)-Zellkulturen, sogenannten Tumororganoiden, die aus einer vitalen Tumorprobe des Patienten gewonnen werden. Durch das RCE-Testverfahren stehen dem behandelnden Arzt zusätzliche Daten zur Verfügung, die es ihm und dem Patienten erleichtern eine optimale Therapieentscheidung zu treffen. So kann so früh wie möglich eine personalisierte Therapie mit voraussichtlich höheren Überlebenschancen und besserer Lebensqualität ausgewählt werden sowie eine wahrscheinlich unwirksame Behandlung samt potentieller ungewollter Nebenwirkungen vermieden werden.